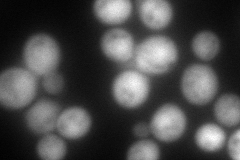
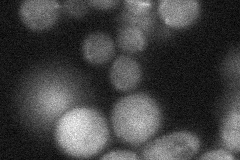
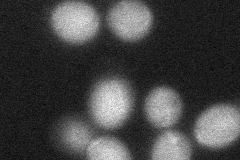
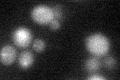

View description
Protein that regulates telomeric length; protects telomeric ends in a complex with Cdc13p and Stn1p
Localization:
Intensity:
Fold change:
Significance:
-
C’ GFP library in SD

below threshold16.04 -
N' NOP1pr-GFP in SD

cytosol,nucleus121.848 -
N' TEF2pr-mCherry in SD
cytosol164.056 -
N' NATIVEpr-GFP in SD
below threshold25.059 -
N' TEF2pr-VC and Cyto-VN in SD
cytosol39.8713 -
C’ GFP library in SD+DTT
cytosolN/AN/ANo -
C’ GFP library in SD+H2O2

cytosolN/AN/ANo -
C’ GFP library in Starvation Media

cytosolN/AN/AYes -
C’ GFP library on the background of Pup2-DaMP

below threshold -
C’ GFP library on the background of CCT mutant

below thresholdN/AN/ANo
